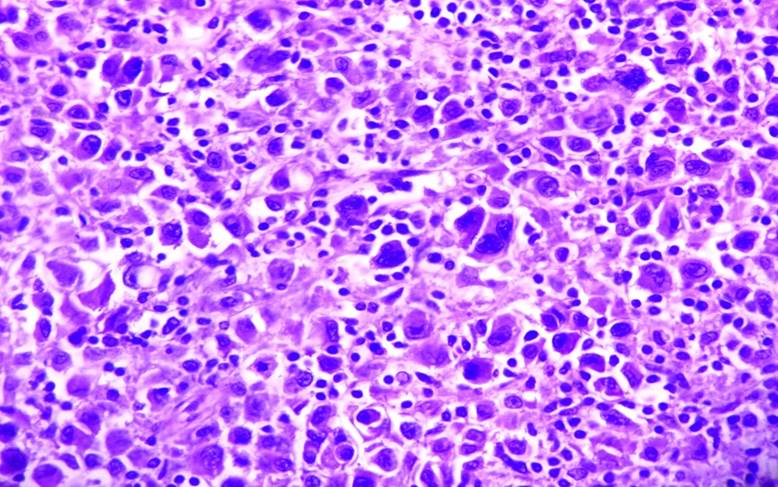

Antecedentes
El melanoma es un cáncer derivado de la proliferación de melanocitos atípicos, con o sin la capacidad de producir pigmento, caracterizado por su gran capacidad de metástasis.1 Constituye solamente entre el 1 y 4% de los cánceres de piel, sin embargo, es responsable de la mayoría de las muertes secundarias a esta neoplasia.2
Además, representa menos del 1% de los casos de cáncer de pene y menos del 0.2% de todos los melanomas.3-5 Ocurre típicamente entre la sexta y séptima década de vida.6 Se han reportado alrededor de 200 casos en la literatura desde el primer caso de melanoma de pene descrito por Muchnison en 1859.7,8
Caso clínico
Paciente masculino de 54 años de edad. Originario del estado de Veracruz, sin antecedentes de importancia tanto heredofamiliares como personales patológicos para padecimiento actual, no padece enfermedades crónico-degenerativas y quien acudió a valoración por síntomas obstructivos del tracto urinario inferior.
Durante la exploración física a nivel de genitales se observa la presencia de fimosis y se palpa a nivel de glande lesión de consistencia pétrea, irregular e indolora. No se palpan adenopatías inguinales y no se observa alguna otra alteración en la exploración física restante.
Se procede a realizar incisión dorsal de prepucio teniendo como hallazgo tumor en glande de aspecto verrugoso, color negro, consistencia pétrea, abarcando hasta meato uretral (Fig. 1 y 2). Se decide tomar biopsia de la lesión y en un segundo tiempo quirúrgico se realiza penectomía total (Fig. 3), se propone realizar linfadenectomía, empero el paciente no acepta por las potenciales comorbilidades.
Reporte histopatológico: Melanoma nodular, multicéntrico, ulcerado, con infiltración a cuerpo esponjoso (2.5cm de profundidad). Borde distal y marginal libre de lesión. Breslow 25 mm, 1 mitosis/mm2 (Fig. 4 y 5)
Figura 4 Microfotografía 40x. Numerosas células melanocíticas atípicas con grandes núcleos hipercromáticos, eosinófilo y abundante citoplasma.

Figura 5 Microfotografía 4x. Neoplasia ulcerada. Melanocitos con disposición en nidos, con migración a epidermis característico de melanoma.
Dentro del seguimiento se observa aumento de volumen a nivel inguinal izquierdo a los 6 meses. Se realiza tomografía abdominopélvica, (Fig. 6) evidenciando patología a nivel inguinal izquierdo. Es valorado por cirugía oncológica ofreciendo lifandectomía con fines de estatificación. El paciente no acepta procedimiento quirúrgico por lo que se envía a oncología médica, iniciando tratamiento paliativo con temozolamida. Persiste con progresión de la actividad tumoral a nivel hepático, esplénico y ganglionar inguinal izquierdo. Nuevo estudio de tomografía evidencia progresión en el número y tamaño de las metástasis hepáticas y esplénicas, se identifican metástasis óseas; lesiones blásticas a nivel de L4, T7 y T9. Oncología medica cambia a tratamiento paliativo con INF alfa 2b y ácido zoledrónico. Finalmente, el paciente fallece 16 meses después del diagnóstico secundario a falla hepática y falla renal.
Discusión
El melanoma es una neoplasia cutánea maligna poco frecuente, pigmentada, plana o exofítica de mal pronóstico por su gran capacidad de producir metástasis y rápida diseminación principalmente por vía linfática, responsable de 75% de las muertes por cáncer de piel.9 Se calcula que la incidencia global del melanoma fue de 1.01/100 mil habitantes.10
El melanoma puede presentarse también como un tumor primario en otros órganos como tracto digestivo, respiratorio, sistema nervioso central, coroides, mucosas bucal o vaginal, independientemente de la localización de las metástasis. El melanoma realiza metástasis a la mayoría de los órganos con una especial predilección a ganglios, pulmón, hígado y cerebro.11 La mayoría de los melanomas se localizan en la piel representando el 95% de los casos y porcentaje restante en mucosa oral o genital, en retina y meninges. Se ha documentado que un 3% de pacientes desarrollan melanomas ocultos (enfermedad metastásica sin evidencia de tumor primario).1
A pesar de que el melanoma puede afectar a cualquier parte del cuerpo humano, la afectación del tracto genitourinario se observa en menos del 1% de los casos.12 Su presentación clínica varía desde máculas, pápulas o placas de tonalidad negra, azul marrón de consistencia firme, nodular hasta ulceradas y de gran tamaño.13 La mayoría se presentan en el glande (55%), seguido del prepucio (28%), cuerpo del pene (9%) y meato uretral (8%).14
El melanoma es un tumor maligno de los melanocitos, células derivadas del neuroectodermo. Es un tumor de mal pronostico porque puede metastatizar a cualquier órgano. El melanoma de pene presenta metástasis tempranamente por vía linfática, sin embargo, las metástasis a hígado, pulmón, hueso, cerebro y otros sitios distantes corresponden a diseminación hematógena.15
Las tasas de supervivencia global a los 2 y 5 años son de 63% y 31%, respectivamente.16 Su etiología sigue siendo desconocida y el diagnóstico se realiza mediante biopsia de la lesión. Ante el examen microscópico se presenta asimetría, desprendimiento de células pigmentadas en la dermis, aumento atípico de las uniones intercelulares al igual que necrosis de los melanocitos.17 Se ha documentado que la ausencia de ulceración es proporcional al aumento de la tasa de supervivencia específica y la supervivencia libre de enfermedad a los 5 años.18
La predicción del curso clínico del melanoma se basa principalmente en el grosor del tumor. La clasificación de Breslow se correlaciona estrechamente con las estadísticas de sobrevida. Los factores pronósticos adversos son espesor (≥3,5 mm), ulceración y diámetro (≥ 15 mm).17 Sin embargo, la evaluación del grosor tumoral por sí sola no es suficiente; otros factores importantes en el pronóstico son la extensión del tumor de la participación de las estructuras locales y si hay evidencia clínica o histopatológica de metástasis en los ganglios linfáticos inguinales o pélvicos, lesiones delgadas (menores 1 mm), pero de alto riesgo, se asocian con niveles de Clark IV o V, ulceración, índice mitótico alto (más de seis por campo de alto poder), invasión linfática o vascular y escasez de melanina en el tumor.19
Tradicionalmente, la estadificación de la enfermedad, la elección del tratamiento y el pronóstico del paciente se han basado en un sistema desarrollado por Bracken et al.,20 con enfermedad en estadio I confinada al pene, estadio II metastásico a los ganglios linfáticos regionales y estadio III que representa diseminación enfermedad.
Hasta la fecha no existe tratamiento estandarizado. El tratamiento sigue siendo quirúrgico mediante penectomía. Anteriormente la regla era la penectomía total y linfadectomía ilioinguinal bilateral.21 Sin embargo, no existe un estándar de tratamiento, se ha reportado que la amputación distal con márgenes de excisión amplios puede ser suficiente, siendo controvertida hoy día la linfadenectomía profiláctica rutinaria en el melanoma peneano.22 La opción de tratamiento más racional parece ser una cirugía radical si es posible junto con la terapia adyuvante.23
La quimioterapia está indicada para el melanoma diseminado. La combinación quimioterapia consistente en seis ciclos de dacarbazina (DTIC), carmustina (BCNU), cisplatino y tamoxifeno presenta el mejor resultado. La tasa de respuesta a la terapia varía entre 15% y 45%.22 Se han descrito esquemas de quimioterapia con un solo agente agentes como dacarbazina, temozolomida o cisplatino.24 Se ha informado que la interleuquina-2 y el interferón alfa-2b mejoran la supervivencia de pacientes seleccionados con buen estado funcional. Finalmente, la terapia blanco se ha centrado en inhibidores moleculares del gen BRAF y C-KIT. La inmunoterapia dirigida contra el factor de crecimiento endotelial vascular usando bevacizumab y los reguladores del sistema inmunitario CTLA-4 y PD-1.25
Conclusión
El melanoma de pene es una enfermedad agresiva, de rápida progresión y con alta mortalidad. El tratamiento consiste en la penectomía total. El papel de la linfadectomía profiláctica de forma rutinaria continúa siendo controversial. Los tratamientos de quimioterapia y radiación son solo paliativos o adyuvantes con resultados variables. Los pacientes con enfermedad metastásica tienen un mal pronóstico y no se ha demostrado que ningún medicamento en monoterapia o en combinación haya ejercido un impacto significativo en la supervivencia de los pacientes.











 nueva página del texto (beta)
nueva página del texto (beta)







